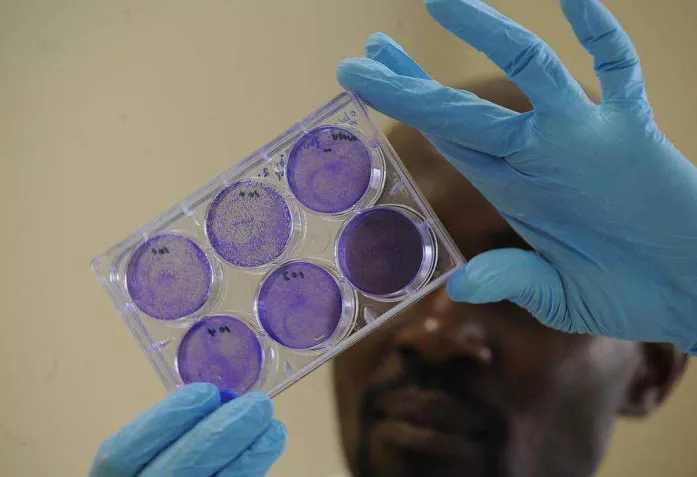

<p>Профессионализм ученых спасает жизни людей и животных (un.org)</p>
Сотрудничая не первый год, две организации станут еще «ближе друг к другу». На этот раз речь идет о совместном доступе к технологиям, с помощью которых ученые надеются разработать стратегии борьбы с опасными вирусными инфекциями.
|
Ayant déjà beaucoup collaboré, deux institutions deviennent «plus soudées». l'Institut suisse de bioinformatique (SIB) va devenir centre de référence pour la FAO (l’Organisation des Nations unies pour l’alimentation et l’agriculture).
О биоинформатике заговорили не так давно. В последние десятилетия в списке новых научных дисциплин появились такие интересные названия, как протеомика, геномика, системная биология, транскриптомика. Биоинформатика – это, по сути, не дисциплина, а набор технологий, с помощью которых можно успешно решать ряд конкретных задач. Молекулярная биология работает сегодня с огромным количеством данных – вручную их уже не обработать, как это делали до появления современных компьютеров. Неизбежно вся информация должна обрабатываться и храниться в цифровом виде. Таким образом, в разных странах мира стали появляться центры биоинформатики.
Швейцарский институт биоинформатики (Swiss Institute of Bioinformatics, SIB), о котором мы писали в прошлом году по случаю его юбилея, имеет в своем активе новое достижение. На этот раз речь идет о расширенном партнерстве со структурой Организации Объединенных Наций.
«ФАО выбрала Швейцарский институт биоинформатики (SIB) в качестве назначенного информационного центра с целью расширить доступ к передовым технологиям в борьбе с опасными вирусными инфекциями, в том числе птичьим гриппом и ящуром, в популяциях домашних и диких животных», - сообщается на сайте Продовольственной и сельскохозяйственной организации ООН.
По этому поводу министр экономики Конфедерации Йоханн Шнайдер-Амманн подчеркнул, что «SIB был выбран благодаря накопленным обширным научным знаниям, а также благодаря уровню оказываемых услуг». Политик добавил, что «выбор ФАО – честь для моей страны, и я этим горжусь», отмечается в коммюнике SIB.
В рамках сотрудничества с ФАО специалисты Швейцарского института биоинформатики разработали инструменты, помогающие улучшить систему раннего выявления, предупреждения и быстрого реагирования на внезапные вспышки трансграничных заболеваний среди домашней птицы и поголовья скота (некоторые из которых могут передаваться человеку). Благодаря работающим в составе SIB 56 исследовательским группам (а это более 650 исследователей, получивших мировое признание в области протеомики, транскриптомики, геномики, системной биологии, структурной биоинформатики, эволюционной биоинформатики, биофизики и популяционной генетики), ФАО получит привилегированный доступ к обширной базе специализированных данных.
Швейцарский институт биоинформатики имеет большой опыт в разработке передового программного обеспечения для исследований в сфере наук о жизни, а также в создании и развитии огромных баз данных, объединяющих, кроме прочего, вирусологическую и эпидемиологическую информацию. Группы исследователей института расположены в кантонах Базель, Берн, Фрибург, Женева, Во, Цюрих и Тичино.
Чтобы стать назначенным информационным центром ФАО, организации следует выполнять одну или несколько из следующих функций:
- стандартизировать технологии, терапевтические и другие вещества, а также методы и процедуры;
- участвовать в совместных исследованиях научного или технического характера;
- координировать деятельность других учреждений;
- предоставлять информацию и консультации научного и технического характера.
Также институт должен иметь опыт предыдущего успешного сотрудничества с ФАО на протяжении не менее двух лет и способствовать реализации приоритетных направлений деятельности ФАО.
«Новые технологии помогают лучше понять биологические угрозы. Это знание поможет нам наилучшим образом содействовать странам в предотвращении угроз и реагировании на возникающие вспышки, а также в сохранении здоровья людей, животных и окружающей среды», - сказал главный ветеринарный эксперт ФАО Хуан Луброт.
В ежемесячном журнале, издаваемым SIB (Protein Spotlight), можно встретить не только сухие научные сведения о белках и их свойствах, но и развернутые статьи научно-популярного характера, многие из которых начинаются в таком стиле: «Что общего между Людвигом ван Бетховеном и швейцарским политиком Паскалем Кушпеном? Музыка? Политика? Ничего подобного: наследственный гемохроматоз (HH). HH возникает вследствие чрезмерного накопления железа в организме, что затрудняет функции важных органов».
Исследователей SIB определенно отличает творческий подход к своей работе, так как на вышеупомянутом сайте можно узнать и о технологии производства искусственного снега для киноиндустрии (один из методов основан на использовании льдообразующего белка), прочитать поэму о белке «купидин», статью о том, как белок-антифриз помогает нототениевидным рыбам не превращаться в ледышки в антарктических водах в зимнее время и многое другое.
Среди последних важных проектов, в которых участвовали ученые SIB, можно упомянуть исследование, позволившее точнее установить связь ожирения с генами человека.
Благодаря работе, проделанной сотнями ученых-участников международного консорциума GIANT («Гигант» - «Генетическое исследование антропометрических признаков»), втрое выросло количество известных местоположений генов, играющих роль в развитии ожирения. Несмотря на важность диет и физических упражнений, результаты исследования генетических образцов более 300 000 человек говорят о большом значении генов в прибавке веса и расположении жира в организме. «Данная работа является первым шагом к определению индивидуальных генов, которые играют ключевую роль в формировании формы и размеров тела», - отмечается в коммюнике на сайте SIB.
Остается надеяться, что специалисты таких учреждений, как Швейцарский институт биоинформатики, в партнерстве со структурами ООН, будут содействовать медикам, генетикам, химикам в совершении новых полезных открытий, благодаря которым человечество победит неизлечимые на сегодня болезни, смертоносные вирусы эбола, птичий грипп и многие другие.

![]()

![]()

![]()